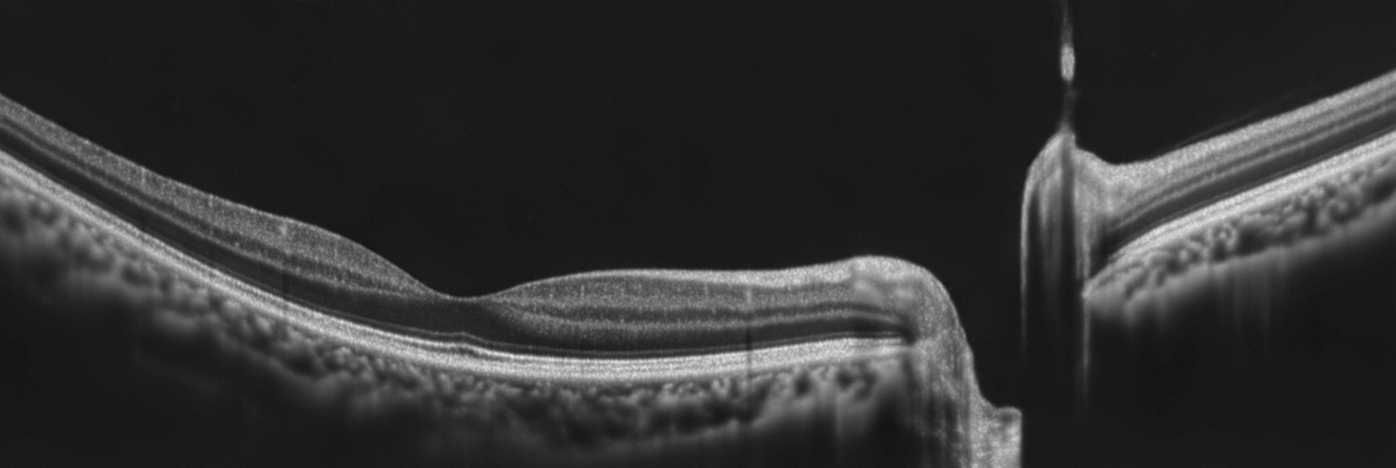

OCT is a new imaging technique that provides high resolution and cross-sectional images of the eye. An OCT scan allows microstructures of the eye to be imaged and shows different colour-coded layers of the retina. It is particularly useful in the diagnosis and management of eye conditions such as age-related macular degeneration, diabetes, macular hole and glaucoma.
OCT uses high definition scanning and 3D imaging to be able to penetrate the soft tissues of the eye, in effect to peel back the layers and see what’s happening within the tissue. The results can be used to identify many eye diseases at an incredible early stage and to monitor for change over time with great sensitivity. Never before has it been so easy to pinpoint the exact location of concern!
The scan takes a matter of minutes, and is painless. It uses light waves, similar to ultrasound to capture the different layers in the eye.